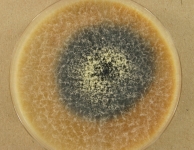

<< back to search
IMAGES:

Search Details
add to cart
| UAMH Number: | 11517 |
|---|---|
| Species Name: | Scytalidium cuboideum |
| Type: | |
| Synonyms: | Alysidium cubodeum / Alysidium cuboideum / Arthrographis cuboidea / Briosia microspora / Coremiella cuboidea / Geotrichum cuboideum / Geotrichum microsporum / Oospora cuboidea |
| Taxonomy: | FUNGI Ascomycota, Leotiomycetes, Helotiales, Helotiaceae |
| Strain History: | E.L. Schmidt (ELS-1) -> Robinson, S. C. (ELS-1) -> UAMH |
| Substrate: | Quercus sp. | Location: | USA Tennessee, Memphis (GEO: 35.15,-90.049) |
| Isolator: | E.L. Schmidt (ELS-1) |
| Isolation Date: | |
| Date Received: | 2011-05-09 |
| Characters: | BIODETERIOGEN/ BIODEGRADATION fungal pigment production for wood spalting applications - Robinson SC, Laks PE, Forest Products Journal 60:490-495, 2011 // BIODETERIOGEN/ BIODEGRADATION fungal pigment production for wood spalting applications - Robinson SC, Tudor D, Cooper PA, Int Biodet Biodegrad 65:1145-1149, 2011 // BIODETERIOGEN/ BIODEGRADATION production of red stain for decorative application - Robinson SC, Tudor D, Cooper PA, Can J For Res 41:1277-1728, 2011 // BIODETERIOGEN/ BIODEGRADATION promoting fungal pigment formation in wood - Robinson SC, Tudor D, Cooper PA, Appl Microbiol Biotechnol 2011 Epub Sep 20 // BIODETERIOGEN/ BIODEGRADATION promoting fungal pigment formation in wood - Robinson SC, Tudor D, Cooper PA, Wood Science and Technology 2011 Epub 17 Jan. // PIGMENT blue-black on CER - (Click for publications citing UAMH 11517) |
| Compounds: | |
| Cross Reference: | ?UAMH 4802 |
| Collections: | Living Strains; Dried Herbarium Material |
| Pathogenic Potential: | Human: yes | Animal: no | Plant: yes |
| Biosafety Risk Group: | RG2 (check the PHAC ePATHogen Risk Group Database for updates) |
| Regulatory Requirements: | Canadian requesters must provide PHAC Pathogen and Toxin License Number (see: https://www.canada.ca/en/public-health/services/laboratory-biosafety-biosecurity/licensing-program.html) and a CFIA Written Authorization for transfer (http://www.inspection.gc.ca/plants/plant-pests-invasive-species/directives/date/d-12-03/eng/1432656209220/1432751554580#app2) prior to shipment. International requesters must provide all legally required importation documentation prior to shipment. This strain is not available for shipment to Cuba, the Democratic People's Republic of Korea, Iran or Syria. Plant pathogenicity status may be verified by using the USDA Agricultural Research Service (ARS) Fungal Database |
| MycoBank ID: | 515403 |
IMAGES:
